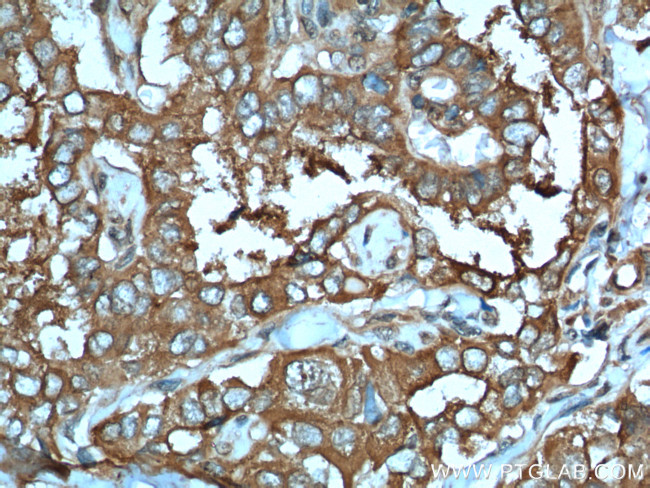
LHCGR Antibody in Immunohistochemistry (Paraffin) (IHC (P))

Search
Proteintech
LHCGR Polyclonal Antibody
{{$productOrderCtrl.translations['antibody.pdp.commerceCard.promotion.promotions']}}
{{$productOrderCtrl.translations['antibody.pdp.commerceCard.promotion.viewpromo']}}
{{$productOrderCtrl.translations['antibody.pdp.commerceCard.promotion.promocode']}}: {{promo.promoCode}} {{promo.promoTitle}} {{promo.promoDescription}}. {{$productOrderCtrl.translations['antibody.pdp.commerceCard.promotion.learnmore']}}
产品信息
26424-1-AP
种属反应
宿主/亚型
分类
类型
抗原
偶联物
形式
浓度
规格
纯化类型
保存液
内含物
保存条件
运输条件
产品详细信息
Immunogen sequence: AGLTRLSLA YLPVKVIPSQ AFRGLNEVIK IEISQIDSLE RIEANAFDNL LNLSEILIQN TKNLRYIEPG AFINLPRLKY LSICNTGIRK FPDVTKVFSS ESNFILEICD NLHITTIPGN AFQGMNNESV TLKLYGNGFE EVQSHAFNGT TLTSLELKEN VHLEKMHNGA FR (49-219 aa encoded by BC157028)
靶标信息
LHCGR encodes the receptor for both luteinizing hormone and choriogonadotropin. It is family 1 of G-protein coupled receptors, FSH/LSH/TSH superfamily, and its basic function is acting as luteinizing hormone/choriogonadotropin receptor (gonadotropin receptor). Regulating the development and function of Leyding cells in males. It also plays a role in male secondary sexual characterdevelopment. Mutations in this gonadotropinreceptor results in disorders of male secondary sexual characteristic development, such as familial male precocious puperty and male pseudohermaphtoditism.
仅用于科研。不用于诊断过程。未经明确授权不得转售。
生物信息学
蛋白别名: HCG receptor; hypergonadotropic hypogonadism; LH/CG-R; LHR; LSH-R; Luteinizing hormone receptor; Lutropin receptor; Lutropin-choriogonadotropic hormone receptor; lutropin/choriogonadotropin receptor
基因别名: Gpcr19-rs1; HHG; LCGR; LGR2; LH-R; LH/CG-R; LH/CGR; LHCGR; LHR; LHRHR; LSH-R; ULG5
UniProt ID: (Human) P22888, (Mouse) P30730
Entrez Gene ID: (Human) 3973, (Mouse) 16867